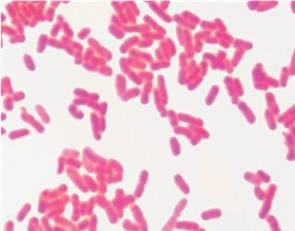
Gram-negative bacteria under microscope

Back
BackIntroduction to Prokaryotic Cells: Structure, Function, and Clinical Relevance
Study Guide - Smart Notes

Introduction to Prokaryotic Cells
Overview of Prokaryotic Domains
Prokaryotic cells are fundamental to life on Earth and are classified into two main domains: Bacteria and Archaea. These domains share several characteristics but also exhibit key differences that are important for their identification and classification.
Bacteria and Archaea are both unicellular organisms lacking a membrane-bound nucleus and organelles.
Bacteria have cell walls containing peptidoglycan, while Archaea have pseudopeptidoglycan.
Both domains differ from Eukarya, which includes all eukaryotic organisms.

Example: Escherichia coli is a bacterium, while Halobacterium is an archaeon.
Prokaryotic Cell Structure and Size
Basic Description and Size Limitations
Prokaryotic cells are typically small, ranging from 0.2 to 750 μm in diameter, with most between 0.5 and 2.0 μm. Their small size is primarily due to the reliance on diffusion for nutrient uptake, which is limited by the surface area-to-volume ratio.
Unicellular and lack membrane-bound organelles.
Most nutrients are obtained through diffusion, limiting cell size.


Additional info: As cells increase in size, their volume grows faster than their surface area, reducing efficiency in nutrient uptake.
Shapes and Arrangements
Prokaryotes exhibit a variety of shapes and arrangements, which are important for identification and classification.
Bacilli (rod-shaped), Cocci (spherical), Vibrio (comma-shaped), Stella (star-shaped), Coccobacilli (ovoid), Spirochetes (spiral-shaped).
Arrangements include single, diplo (pairs), strepto (chains), staphylo (clusters), and palisade (side-by-side clusters).
Pleomorphic bacteria can change shape, aiding survival and transmission.

Example: Staphylococcus aureus forms grape-like clusters, while Streptococcus pyogenes forms chains.
Binary Fission
Prokaryotic cells primarily reproduce by binary fission, a simple form of asexual reproduction.
DNA is replicated.
The cell elongates and chromosomes are separated.
A septum forms, dividing the cell into two daughter cells.

Extracellular Structures and Cell Envelopes
Plasma Membrane Structure and Function
The plasma membrane is a thin, flexible phospholipid bilayer that acts as a selective barrier, controlling the movement of substances in and out of the cell. It also serves as a site for metabolic reactions, including ATP synthesis.
Composed of phospholipids and proteins (transporters, anchors, receptors, enzymes).
Exhibits selective permeability: small, noncharged molecules diffuse freely; ions and large molecules require transport proteins.


Membrane Fluidity
Membrane fluidity is essential for cell function and is influenced by temperature and fatty acid composition.
Warmer temperatures increase fluidity; colder temperatures decrease it.
Unsaturated fatty acids enhance fluidity; saturated fatty acids make the membrane more rigid.
Bacterial vs. Archaeal Membranes
Bacterial and archaeal plasma membranes differ in their lipid composition and structure.
Bacteria: linear fatty acids, ester linkages, always bilayers.
Archaea: long-branched isoprene lipids, ether linkages, can form monolayers (especially in extreme environments).

Cell Wall Structure and Function
The cell wall provides rigidity and protection. Bacteria use peptidoglycan, while archaea use pseudopeptidoglycan.
Peptidoglycan consists of glycan chains cross-linked by peptides.

Gram Staining and Clinical Relevance
Gram staining differentiates bacteria based on cell wall structure, which is clinically important for diagnosis and treatment.
Gram-positive: Thick peptidoglycan, stains purple, no outer membrane.
Gram-negative: Thin peptidoglycan, outer membrane with lipopolysaccharide, stains pink.

Cell Feature | Gram-Negative | Gram-Positive |
|---|---|---|
Outer membrane | Yes | No |
Lipid A (endotoxin) | Yes | No |
Porins | Yes | No |
Teichoic acids | No | Yes |
Peptidoglycan | Thin (10–20%) | Thick (70–80%) |
Gram stain color | Pink | Purple |
Resistance to drying | No | Yes |
Penicillin susceptibility | Low | High |

Acid-Fast Bacteria
Acid-fast staining detects mycolic acid in cell walls, identifying genera such as Mycobacterium and Nocardia. Acid-fast bacteria are slow-growing and require long, multidrug therapies due to their impermeable cell walls.

Mycoplasma and L-Forms
Mycoplasma species lack a cell wall and are pleomorphic, while L-forms are bacteria that have lost their cell wall. Both can be resistant to antibiotics targeting cell wall synthesis.
Transport Mechanisms in Prokaryotic Cells
Passive Transport
Passive transport does not require energy and includes diffusion and osmosis.
Simple diffusion: Movement of small, noncharged molecules down their concentration gradient.
Facilitated diffusion: Uses membrane proteins to transport substances along their gradient.

Osmosis
Osmosis is the diffusion of water across a selectively permeable membrane, driven by solute concentration differences.
Isotonic: No net water movement.
Hypertonic: Water leaves the cell, causing plasmolysis.
Hypotonic: Water enters the cell, possibly causing lysis if the cell wall is damaged.

Active Transport
Active transport requires energy to move substances against their concentration gradient. Prokaryotes use three main mechanisms:
Primary active transport: Uses ATP directly (e.g., Na+/K+ pump).
Secondary active transport: Uses ion gradients (symport and antiport).
Phosphotransferase system: Transfers a phosphate group to the transported substance (e.g., glucose uptake).

External Structures for Adhesion, Movement, and Protection
Flagella
Flagella are filamentous structures used for motility. They are composed of flagellin and anchored differently in Gram-positive and Gram-negative bacteria.
Enable movement via a run-and-tumble system.
Types of taxis: chemotaxis (chemicals), phototaxis (light), aerotaxis (oxygen).
Arrangements: monotrichous (single), lophotrichous (tuft), amphitrichous (both poles), peritrichous (all over).


Periplasmic Flagella (Axial Filaments)
Periplasmic flagella are found in spirochetes and allow corkscrew motion, aiding movement through viscous environments.

Fimbriae and Pili
Fimbriae are short, bristle-like structures that aid in adhesion and biofilm formation. Pili are longer, less numerous, and involved in adhesion, movement, and gene transfer (conjugation).


Glycocalyx
The glycocalyx is a carbohydrate-rich layer that protects bacteria from desiccation, antibiotics, and immune responses. It can be a loosely associated slime layer or a tightly bound capsule.

Intracellular Structures
Nucleoid
The nucleoid is the region where the single, circular chromosome of prokaryotes is located. It is not membrane-bound.

Ribosomes
Prokaryotic ribosomes (70S) are composed of a large (50S) and a small (30S) subunit. They are responsible for protein synthesis and are structurally distinct from eukaryotic ribosomes, supporting the endosymbiotic theory.

Cytoskeleton
The prokaryotic cytoskeleton is made of protein filaments that provide structural support and help maintain cell shape.
Inclusion Bodies
Inclusion bodies are storage sites for nutrients and other substances. Examples include carboxysomes (carbon fixation) and magnetosomes (magnetic iron storage).
Endospores
Endospores are dormant, highly resistant structures formed by certain bacteria (e.g., Bacillus, Clostridium) to survive harsh conditions. They can persist for long periods and are difficult to eradicate in healthcare settings.
Formed through sporulation: DNA is packaged, surrounded by protective layers, and released.
Germinate into vegetative cells when conditions improve.
Example: Bacillus anthracis (anthrax), Clostridium tetani (tetanus).
